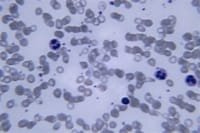
Zacharias Janssen

-
Jugó un papel importante en el desarrollo de la teoría de la célula, a través del desarrollo del primer microscopio primitivo, indica el Departamento de Biología de la Universidad de Miami. Zacharias Janssen era un fabricante de anteojos de Middleburg, Holanda.
Jugó un papel importante en el desarrollo de la teoría de la célula, a través del desarrollo del primer microscopio primitivo, indica el Departamento de Biología de la Universidad de Miami. Zacharias Janssen era un fabricante de anteojos de Middleburg, Holanda. -
 destacó por sus estudios microscópicos, si lo hizo por la aplicación de las lentes en diversos aparatos como el telescopio y este microscopio. Este microscopio (20 cms. de alto por 5,5 cms de diámetro) posee un cilindro externo de cartón, forrado de cuero verde, que alberga en el extremo inferior la lente objetivo.
destacó por sus estudios microscópicos, si lo hizo por la aplicación de las lentes en diversos aparatos como el telescopio y este microscopio. Este microscopio (20 cms. de alto por 5,5 cms de diámetro) posee un cilindro externo de cartón, forrado de cuero verde, que alberga en el extremo inferior la lente objetivo. -
 Giovanni Faber acuñó el nombre ‘microscopio’ para el microscopio compuesto de Galileo Galilei.
Giovanni Faber acuñó el nombre ‘microscopio’ para el microscopio compuesto de Galileo Galilei. -
 Robert Hooke hace una teoría de “células”, el describe a las “células” como pequeños organismos que crean al ser humano. Mientras Hooke observaba un corcho, se da cuenta de pequeños agujeros, el nombre de células se le ocurrió por que le recordaban de (a) los cuartos en que los monjes se hospedan, celdas.
Robert Hooke hace una teoría de “células”, el describe a las “células” como pequeños organismos que crean al ser humano. Mientras Hooke observaba un corcho, se da cuenta de pequeños agujeros, el nombre de células se le ocurrió por que le recordaban de (a) los cuartos en que los monjes se hospedan, celdas. -
 Antonie van Leeuwenhoek construye un microscopio simple con una lente para examinar la sangre, la levadura y los insectos. Es el PRIMERO en describir células y bacterias. Inventa nuevos métodos para hacer lentes que permiten aumentos de hasta 270 veces
Antonie van Leeuwenhoek construye un microscopio simple con una lente para examinar la sangre, la levadura y los insectos. Es el PRIMERO en describir células y bacterias. Inventa nuevos métodos para hacer lentes que permiten aumentos de hasta 270 veces -
Joseph Jackson Lister reduce la aberración esférica (que produce imágenes imperfectas) mediante el uso de varias lentes débiles juntas a ciertas distancias para dar un buen aumento sin difuminar la imagen.
-
 Estableció la microbiología quien propuso la teoría de la infección como enfermedad, causada por estos animalitos móviles.
Estableció la microbiología quien propuso la teoría de la infección como enfermedad, causada por estos animalitos móviles. -
Empresas en Alemania como Zeiss y una empresa americana fundada por Charles Spencer comenzaron a producir instrumentos ópticos finos. También podemos mencionar a Ernst Abbe, que realizó un estudio teórico de los principios ópticos, y a Otto Schott, que realizó investigaciones sobre el vidrio óptico
-
 Ernst Abbe Escribe una fórmula matemática que correlaciona el poder de resolución con la longitud de onda de la luz. La fórmula de Abbe permite calcular la resolución máxima teórica de un microscopio.,
Ernst Abbe Escribe una fórmula matemática que correlaciona el poder de resolución con la longitud de onda de la luz. La fórmula de Abbe permite calcular la resolución máxima teórica de un microscopio., -
 inventado por Richard Adolf, que era capaz de observar nanopartículas de 4 nm
inventado por Richard Adolf, que era capaz de observar nanopartículas de 4 nm -
 En los últimos tiempos, la evolución del microscopio se ha ralentizado, ya que los principios ópticos son bien conocidos y, en cierta medida, se han alcanzado los límites ópticos. La mayoría de los microscopios siguen los mismos principios estructurales que describen los microscopios monoculares, monobinoculares y estereobinoculares.
En los últimos tiempos, la evolución del microscopio se ha ralentizado, ya que los principios ópticos son bien conocidos y, en cierta medida, se han alcanzado los límites ópticos. La mayoría de los microscopios siguen los mismos principios estructurales que describen los microscopios monoculares, monobinoculares y estereobinoculares.
La invención del microscopio permitió a los científicos y estudiosos estudiar las criaturas microscópicas del mundo que les rodea.
Want to make a timeline like this?
Use Timetoast to turn dates, events, milestones, and phases into a clear visual timeline you can build and share. Timetoast is a timeline maker for work, school, research, and stories.